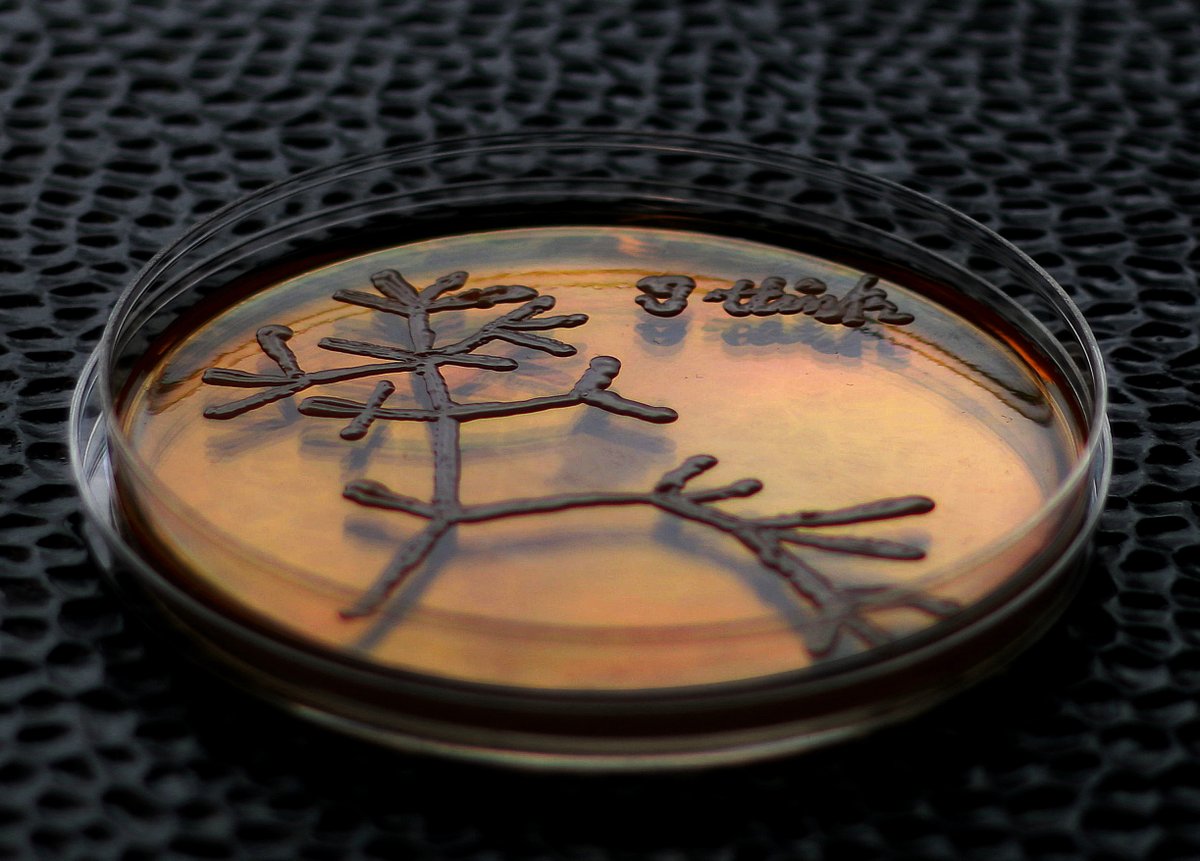
The 2025 Speciation Gordon Research Conference (March 2-7 2025) is open for registration! We have a great line up of speakers that should be of interest to many, including people that don't think they work on speciation per se. Please retweet! grc.org/speciation-con…

Linyi Zhang
@lin_yizhang
Assistant professor at George Washington University
ID: 3987227178
https://zhanglabgwu.weebly.com/ 23-10-2015 04:08:26
803 Tweet
462 Takipçi
337 Takip Edilen

Very useful collection of genomics tutorials by European Reference Genome Atlas knowledge.erga-biodiversity.eu

Scientists at Rice University discover new parasitic wasp species on campus oak trees yourweather.co.uk/news/science/s… via Meteored UK


Does intra-locus conflict between the life cycles lead to genome-wide signatures of selection? Find out in this study led by Meng Yuan 袁梦 !!








our new genome paper on the (weird) tuliptree scale is now out in g3! i've never worked on an insect with an alternative sex determ. system before my time in the Mongue lab, but needless 2 say... i will always be impressed and horrified of what bugs can do academic.oup.com/g3journal/adva…

See our new paper on phylogenomic insights and geographic distribution of the New World genus Amphibolips Reinhard (#Hymenoptera: Cynipidae, Cynipini) using #UltraConservedElements doi.org/10.1111/syen.1… Royal Entomological Society Wiley Ecology & Evolution




New paper by former #RiceEEB PhD student, Pedro Brandão-Dias F Pinto! Great #eDNA colllaboration between Rice University & University of Notre Dame! "Comparing the Fate of eDNA by Particle Sizes and Molecule Lengths in Recirculating Streams" - @WileyEcolEvol onlinelibrary.wiley.com/doi/10.1002/ed…